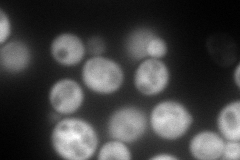
YML131W
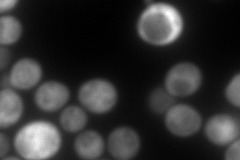
YML131W
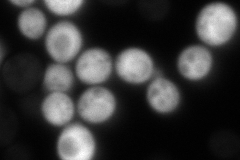
YML131W
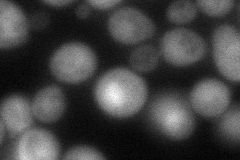
YML131W
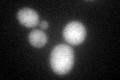
YML131W
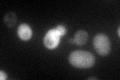
YML131W

View description
Putative protein of unknown function with similarity to medium chain dehydrogenase/reductases; expression induced by stresses including osmotic shock, DNA damaging agents, and other chemicals; GFP-fusion protein localizes to the cytoplasm
Localization:
Intensity:
Fold change:
Significance:
-
C’ GFP library in SD

cytosol45.13 -
N' NOP1pr-GFP in SD
cytosol214.312 -
N' TEF2pr-mCherry in SD
cytosol350.573 -
N' NATIVEpr-GFP in SD
cytosol39.6896 -
N' TEF2pr-VC and Cyto-VN in SD
cytosol77.4858 -
C’ GFP library in SD+DTT
cytosol50.61.12No -
C’ GFP library in SD+H2O2

cytosol59.351.31No -
C’ GFP library in Starvation Media
cytosol122.292.7Yes -
C’ GFP library on the background of Pup2-DaMP

cytosol -
C’ GFP library on the background of CCT mutant

cytosol47.26761.04723No
